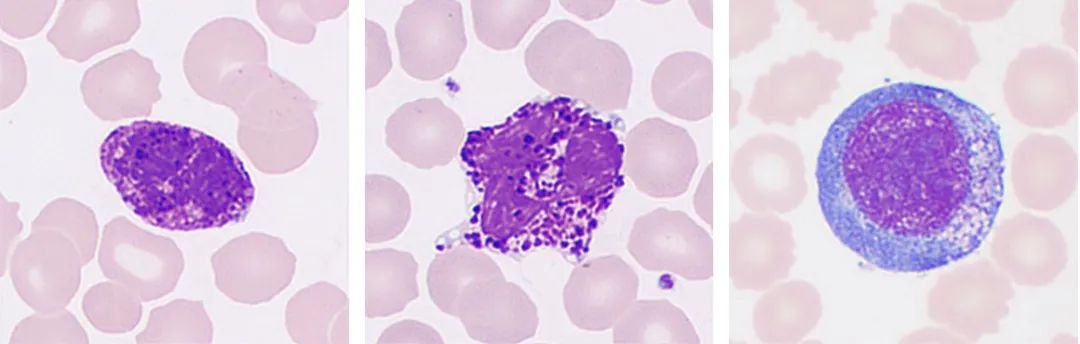
1694658653155052979.jpg

拥抱医疗大模型 迈瑞医疗再度携手腾讯引领医疗器械数智化升级
9月8日,在2023腾讯全球数字生态大会上,迈瑞医疗与腾讯健康达成战略合作,双方将依托云计算、医疗大模型等数字技术,携手推进医疗器械产业的数智化升级。迈瑞医疗研发副总裁李新胜、中国区营销总经理赵宇翔,腾讯健康总裁吴文达、智慧医疗总经理张国栋分别代表双方团队签署战略合作协议。

(迈瑞医疗携手腾讯,拥抱医疗大模型)
据了解,迈瑞医疗与腾讯的合作始于八年前,双方在体外诊断领域联手共同研发的“全自动外周血细胞形态学分析仪”,极大地提升了阅片的准确率和整体效率,打破了阅片机市场仅有一家进口品牌“独大”的局面,成为“医疗+AI”融合创新的标杆。
对于本次的合作升级,迈瑞医疗研发副总裁李新胜表示,双方将在腾讯擅长的大语言模型以及云计算等方面开展更深入的合作,不仅局限于体外诊断,还将拓展到重症、急诊、麻醉等临床科室,输出更多有临床价值的成果。
携手研发阅片机获丰硕成果
早在2016年,迈瑞医疗与腾讯的算法工程师团队就已有交流接洽,并在人工智能阅片领域找到了契合点。依托腾讯在机器学习、计算机视觉等领域的前沿算法,以及顶级研究科学家的经验和数字解决方案能力,结合迈瑞医疗在玻片处理、成像系统、集成设计、临床专家、海量数据等方面的产业势能,双方联合研发“全自动外周血细胞形态学分析仪”(简称:阅片机)。阅片机融入了AI算法,清晰还原细胞立体结构和细节,大大提升阅片的准确率和整体效率,成为国内体外诊断行业首个进入三类创新医疗器械特别审查程序的AI类产品,填补了国产空白。
(迈瑞医疗与腾讯携手研发AI阅片,为血液疾病筛查提效)
据李新胜介绍,经过大规模的AI阅片和人工阅片的对比实验,初步证明阅片机能够显著提升阅片的准确性和效率,医生的平均阅片时间从25-30分钟,大幅缩短至半分钟。从市场表现来看,该阅片机新产品自去年上市以来,销量已经超过了过去十年,在包括意大利、西班牙的全球400多家医院完成装机,并受到国际客户高度认可,市场表现远优于国外同行。
升级医疗大模型开展深度合作
与此同时,作为国内互联网龙头,腾讯在人工智能和云计算领域的探索也从未止步。在2023腾讯全球数字生态大会上,腾讯正式发布了具有超千亿参数规模的全链路自研混元大模型,并进一步公布医疗大模型的研发与应用布局,至此,迈瑞医疗与腾讯的合作也进入“大模型时代”。
据腾讯杰出科学家、天衍实验室主任郑冶枫介绍,腾讯混元大模型具备强大的中文创作能力、复杂语境下的逻辑推理能力以及可靠的任务执行能力。在此基座模型上,通过持续加入涵盖285万医学实体、1250万医学关系,覆盖98%医学知识的医学知识图谱和医学文献,使大模型进一步掌握了专业的医学知识。
据了解,医疗大模型可以被应用在包括文案生成、智能问答、病历结构化和检索、影像报告和辅助诊断等场景,嵌入医疗环节全流程,在科室导诊、医生推荐、预问诊、医患对话、病历自动生成和智能院务客服等应用中,实现医疗服务水平和质量的全面提升。
而迈瑞医疗过去十几年在大数据的使用和分析上也从未停止探索的步伐,并且已经从原来的单纯看生理参数,拓展到目前整个诊疗过程中的多模态数据处理。在此过程中,公司对于AI技术在医疗设备中的广泛应用程度甚至是领先于进口品牌。
在迈瑞医疗与腾讯健康本次合作升级后,双方将基于腾讯大模型的计算和指引,在医疗器械产业数字化上全面合作,探索医疗大模型的智能化应用,把AI+大模型拓展到更多应用医学领域,如重症、急诊、麻醉科等科室。
此外,腾讯在云计算、人工智能、大数据、安全等核心技术优势,也将进一步与迈瑞医疗的产研体系数字化升级结合,加速医疗器械智能化、信息化产品研发迭代。迈瑞医疗基于人工智能、云计算技术的“瑞智联”、“瑞影云++”、“迈瑞智检”等核心智慧医疗业务,将与腾讯云深度结合,打造国产医疗器械数字化升级标杆,并携手拓展全球市场。
整合优质资源 引领医疗器械高质量发展
对于此次双方合作的意义,迈瑞医疗中国区营销总经理赵宇翔表示,两家企业的愿景和使命十分相像。腾讯的愿景是“科技向善”,迈瑞医疗的使命是“普及高端科技,让更多人分享优质生命关怀”。希望通过全面的战略合作,强强联合,双方共同探索基于患者大数据的人工智能技术和产业化落地,造福人类。目前,全球医药卫生领域普遍存在医务人手不足、劳动力紧缺的问题,医院的效率逐渐难以应对患者老百姓对健康的高度需求。“相信我们合作推出的相关产品走进医院之后,会让医院的诊断更加准确,患者的舒适度得到很好的改善,这是我们努力的方向。例如,围绕患者在急麻重症治疗,以及检查检验诸多方面,迈瑞有智能化的硬件和三瑞信息化软件,搭载腾讯大模型和人工智能技术,可以摸索更好的商业应用模式。”
腾讯健康智慧医疗总经理张国栋则强调,腾讯与迈瑞两大头部企业的深度合作,将带来1+1>2的倍增效果,期待双方在这个过程中撞出更多火花,找到更好的智能化场景,给行业和用户带来更多的创新产品。
实际上,今年以来,迈瑞医疗已经与国药控股、华润医药、诺唯赞生物、上药控股等众多国内外知名企业积极开展合作,以期从多方位助力医疗器械行业高质量发展。
2023年2月,迈瑞医疗先后官宣与国药器械和华润医药的战略合作。据了解,迈瑞医疗与国药器械将在医疗器械采购、医疗服务领域建立长期、稳定的战略合作伙伴关系,从而进一步提升整体运营效率、降低运营成本,实现互惠互利、共同发展。而在国家深化医药卫生体制改革及促进医药产业健康发展的大背景下,迈瑞医疗与华润医药将在业务合作、市场营销、产业推动等多个领域携手发展。
在体外诊断领域,今年5月,迈瑞医疗与海外知名IVD企业诺唯赞生物开展了深入战略合作,携手打造感染筛查及呼吸道病原体检测的整体自动化解决方案,从而满足检验自动化、信息化、智能化等整体方案需求,优化检测流程,提升质量与效率,为患者提供更好的诊疗服务。7月,迈瑞医疗与上药控股签署战略合作,双方将通过整合现有资源进行项目推广,共同探索创新营销模式,并在医疗设备、耗材、检验IVD等方面建立长期全面的合作关系。
作为国产医疗器械龙头企业,迈瑞医疗长期积极整合全球范围的前沿技术和资源,寻求与更多行业内优秀公司的合作机会,期待为患者提供更好的医疗服务。未来,迈瑞医疗将继续践行“普及高端科技,让更多人分享优质生命关怀”的使命,为守护人类生命健康贡献更多力量。
免责声明:本网站有部分内容均转载自其它媒体,转载目的在于传递更多信息,并不代表本网赞同其观点和对其真实性负责,若因作品内容、知识产权、版权和其他问题,请及时提供相关证明等材料并与我们联系,本网站将在规定时间内给予删除等相关处理.
猜你喜欢






